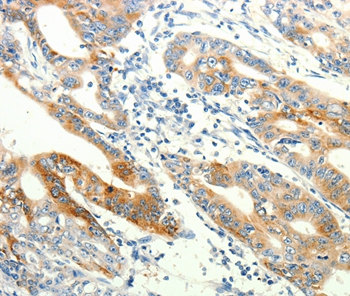

Anti-TRPA1 (Internal) Antibody
119-11302
TargetTRPA1
Product group Antibodies
Overview
- SupplierRayBiotech
- Product NameRabbit Anti-Human TRPA1 (Internal)
- Delivery Days Customer4
- CertificationResearch Use Only
- ClonalityPolyclonal
- Concentration1 mg/ml
- Gene ID8989
- Target nameTRPA1
- Target descriptiontransient receptor potential cation channel subfamily A member 1
- Target synonymsANKTM1; ankyrin-like with transmembrane domains 1; FEPS; FEPS1; transformation-sensitive protein p120; transient receptor potential cation channel subfamily A member 1; wasabi receptor
- HostRabbit
- Protein IDO75762
- Protein NameTransient receptor potential cation channel subfamily A member 1
- Scientific DescriptionTRPA1 Rabbit anti-Human Polyclonal (Internal) (Unconjugated) Antibody, (50 ug)
- Storage Instruction-80°C
- UNSPSC12352203